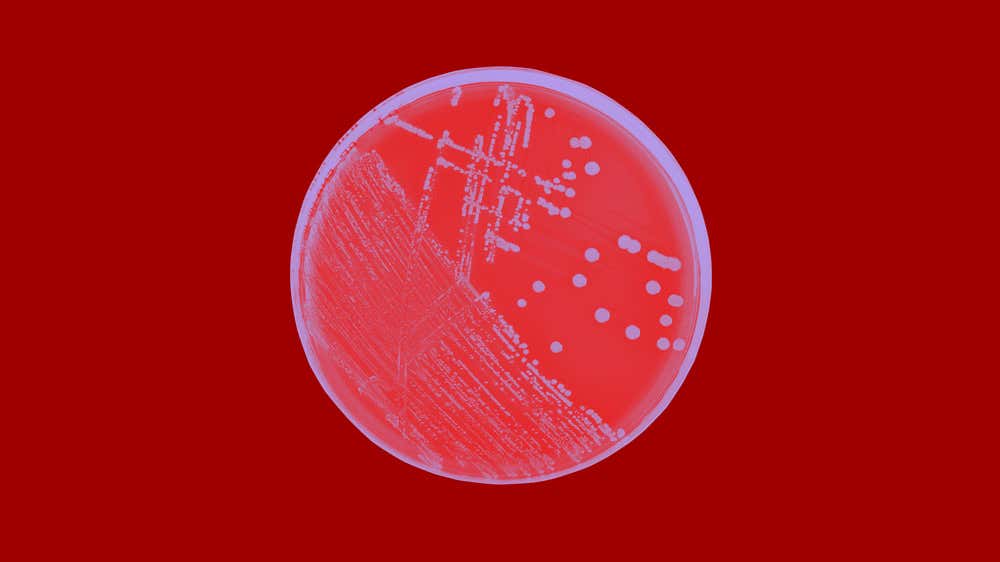

J&J Medical Cloud is a tailored platform offering clinical tools, expert insights, and the latest updates to empower your practice.

Select your country and create your J&J Medical Cloud account to access restricted content and services.
At J&J, our purpose is to make cancer a manageable and, ultimately, curable condition. Learn more about our precise areas of focus.
At J&J, we are spearheading a new era for PH, working to transform the disease into a long-term manageable condition, so that patients can live a normal life.
At J&J, we believe that more ambitious targets in IBD are within reach. Learn more about how we support ambitious treatment objectives in Crohn’s disease and ulcerative colitis.
At J&J, our mission is to help every person with HIV live longer, healthier and happier lives by supporting the health needs that make them unique – whatever they may be.
To find details of your local J&J Medical Cloud information team, please click to access and select your country.
Your health matters. At J&J withMe, we are committed to providing reliable information, personalized resources, and compassionate support to help you navigate your healthcare journey with confidence.

.jpg?width=3218&height=1810&format=jpg&quality=60)

